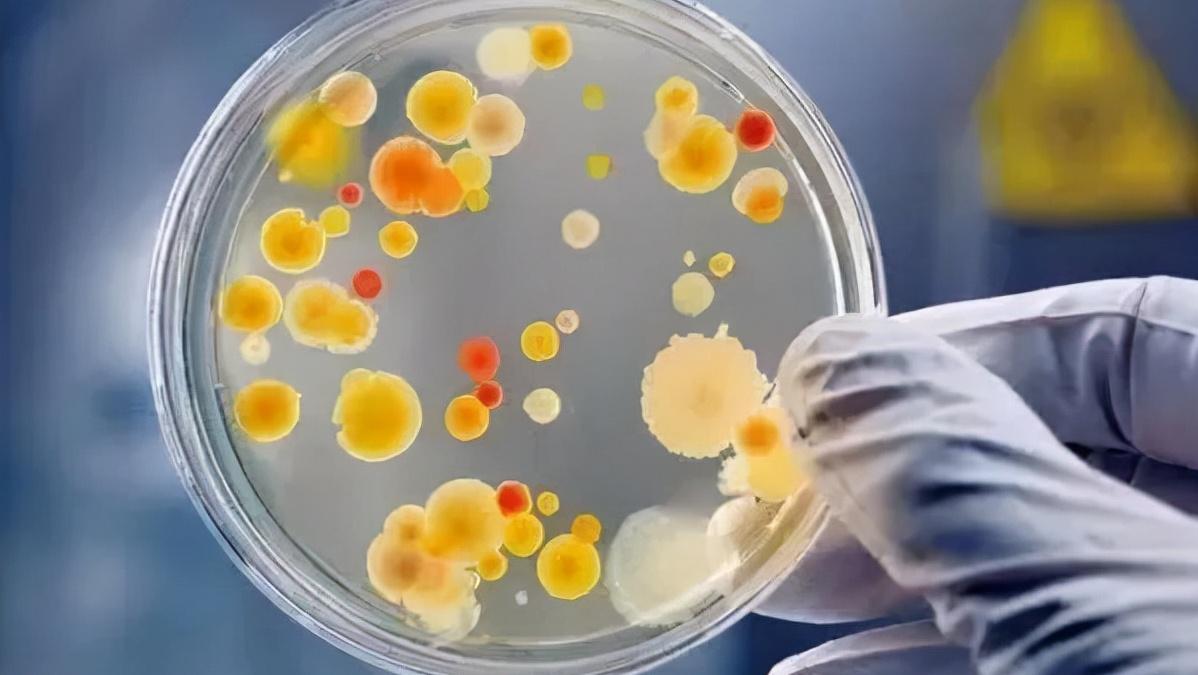
明星代言的酵素哪个比较好,酵素明星代言

提起酵素,你的第一印象是什么呢?
酵素自从走进我们的生活日常,一直扮演着重要的角色。但是大家对这类产品的评价却不尽相同、褒贬不一。
有人说酵素能瘦身,也有说能美白等等,市面上各式各样的酵素类产品五花八门,价格也从十几块钱到几千,甚至上万。
那么酵素类产品,究竟有没有大家说的那么神奇呢?

第一、从一位阿姨的亲身经历说起
说这个问题之前呢,先说一个真实的事例。
大约在2个月以前, 杭州的一位63岁的阿姨,身患便秘多年,三年前开始吃酵素以后通畅了很多。
近日,在一次结肠镜检查时,医生发现王阿姨的肠子布满了棕黑色的花纹,像“蛇皮”一样。结果患上了结肠黑变病。
吃了酵素之后,导致自己的肠道变黑,这个确实挺吓人的 !
随后这件事经过媒体的渲染、发酵,很快就登上了各大平台的热搜榜,而酵素类产品随即被推上了风口浪尖。
那么,酵素类产品真的那么“恐怖”吗?
很快!这位阿姨的诊断报告随之出炉,诊断表明:他吃的酵素里面是含有“禁止类添加元素” 蒽醌类泻药, 这类添加剂是不能被添加的!
也就是她买的这个产品是没有经过严格检测,根本就不合格!也就是说经销商为了达到自己承诺,不惜利用这种手段来达到效果。
所以,酵素伤身主要取决于,你买的产品是否是合格的、正规的。如果像上面这位阿姨买的这类含有“禁止类成分”的产品,那肯定是伤身的。反之,正规合格的,基本上是没有任何问题的。
第二、怎么去选择合格的酵素产品呢?
在说这个问题之前呢,大家首先要明白酵素到底是什么?
最早的解释是一种酶,也就是我们身体必须的一种元素。这种元素会随着年龄的增长,逐渐减少。尤其是人的年龄到了40岁以后,会流失得非常明显。
因此呢,如何及时有效地补充流失的酶,就成了很多人的需求。
这个时候,国外率先研发出了酵素这种产品。也就是能够在一定程度上,去缓和酶流失的现象。最早出现在日本,后来逐渐风靡欧美。现在我们的宝岛台湾,也是非常流行饮用酵素类的产品。
因此,我们也可以看出合格的酵素类产品,还是非常受欢迎的。
酵素自从被人类发掘并运用于生活,其作用得到了广泛的认可 并且进一步有数据表明:酵素类产品,对于膳食纤维以及一些微量元素的吸收,也是起到了促进的作用。并且在调节人体机能、新陈代谢、肠道调理等方面 都有突出的表现。
实际上,酵素是一种健康食品, 是各种酶的集合物,然而不仅仅就等于酶,酵素里面还含有各种各样丰富的营养物质:各种微量元素,维生素,益生菌,膳食纤维等等!服用酵素所得到的效果也是因人而异,而这关键是体质的问题,但是只要你坚持服用合格的产品,它会慢慢改善你的症状,达到理想的效果!

第三、可参考以下的几点。
1、要仔细地去审核产品的配料、检测报告等。
解释一下:酵素是发酵类产品,现在市面上出现了不少用果汁勾兑的,价格很低、包装很漂亮,但是这个不建议去购买。
配料组成,一般是果蔬类、菌类、糖类为最基本的组成。
另外就是检测报告,像国家承认的一些检测机构,比如ISO、HACCP、SGS等等,有这些检测认证,还是能够增加信任感的。

2、不要盲目地去看销量、明星代言、价格。
有时候商家为了营造一种产品受欢迎的程度, 会用一些技术手段,达到产品火爆的场景。
但是咱们消费者,还是要理性地去看待。而且,价格看上去非常的诱人,这些往往成为大家下单的主要因素。
3、如果你是在厂家直接购买的,同样也要深入地了解一下他的生产工艺。
这个是非常有必要的!如果他的环节和工艺都达到了标准的要求,那么你基本就可以选择长期的信任这个厂家了,完全没有必要再去更换了。
目前,我们国内还是有几个非常不错的酵素生产厂家的,大家可以去详细地了解一下。